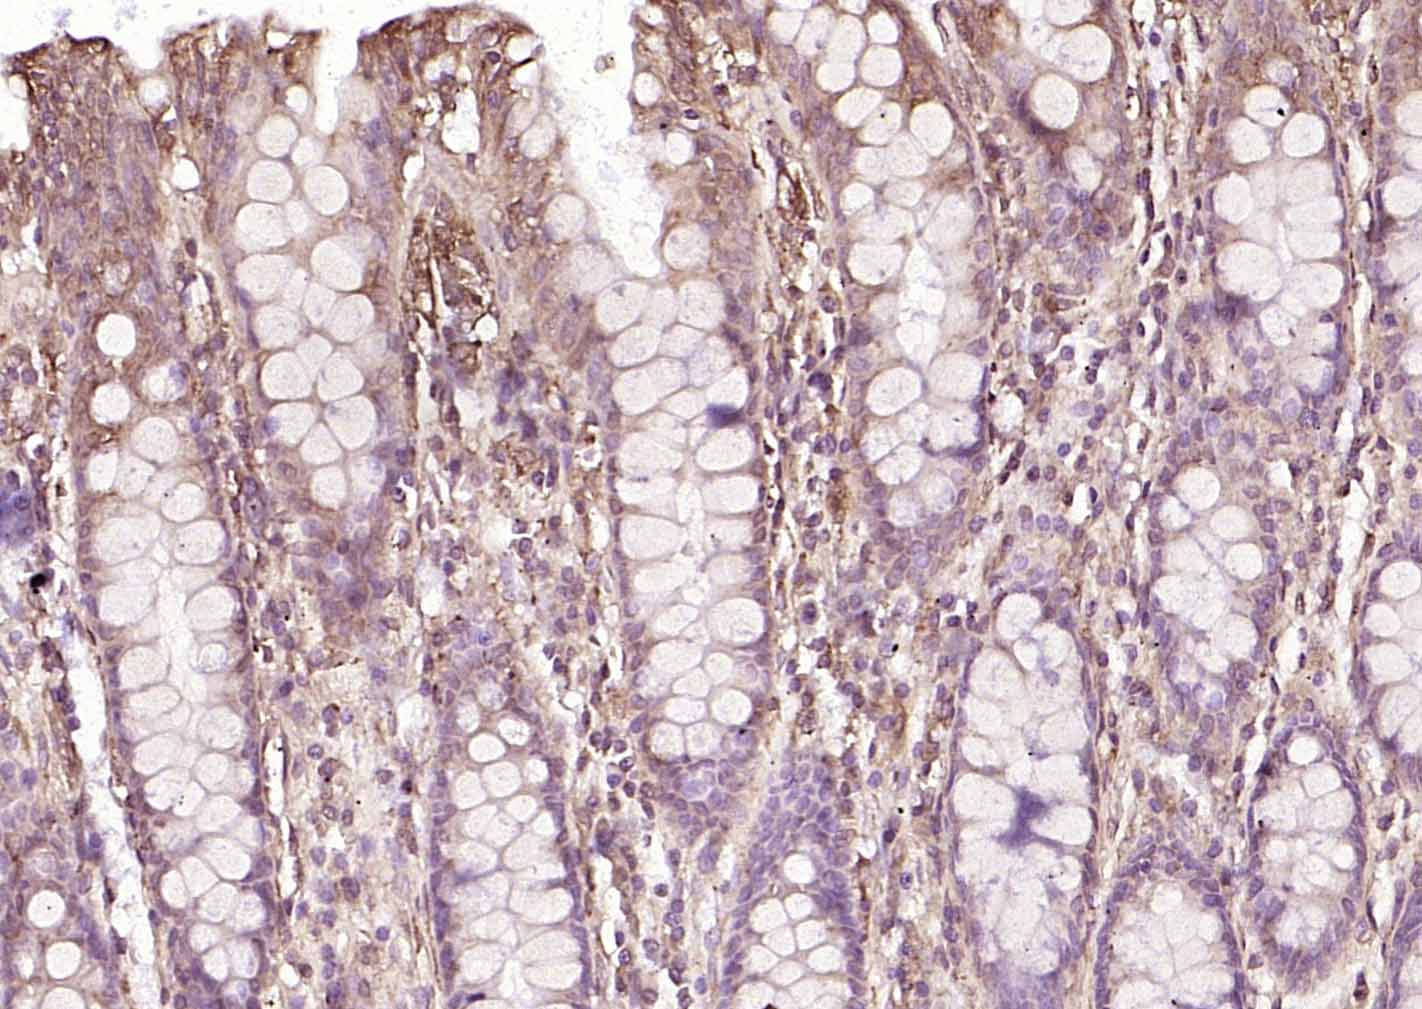
P4HB Recombinant Mouse mAb(bsm

相关产品推荐更多 >

Deltex 1 Rabbit pAb, Cy7 conjugated(bs-0399R-Cy7)-100ul
¥2980
DPP4/CD26 Rabbit pAb, APC-Cy7 conjugated(bs-2570R-APC-Cy7)-100ul
¥2980
Hyaluronidase3 Rabbit pAb, FITC conjugated(bs-5889R-FITC)-100ul
¥2980
CHRM4 Rabbit pAb, HRP conjugated(bs-20372R-HRP)-100ul
¥2980
DDAH1 Rabbit pAb(bs-11997R)-50ul/100ul/200ul
¥1180
万千商家帮你免费找货
0 人在求购买到急需产品
- 详细信息
- 技术资料
- 应用范围:
产品信息以Bioss网站为准
- 规格:
50ul/100ul/25ul
| 规格: | 50ul | 产品价格: | ¥1400.0 |
|---|---|---|---|
| 规格: | 100ul | 产品价格: | ¥2500.0 |
| 规格: | 25ul | 产品价格: | ¥800.0 |
| 产品编号 | bsm-60312M |
| 英文名称 | P4HB Recombinant Mouse mAb |
| 产品应用 | WB=1:500-1000, IHC-P=1:100-500, IHC-F=1:100-500, ICC/IF=1:50-100, IF=1:100-500 Not yet tested in other applications. |
| 交叉反应 | Human (Rat) |
| 抗体来源 | Mouse |
| 亚型 | IgG |
| 性状 | Liquid |
| 纯化方法 | affinity purified by Protein G |
| 克隆类型 | Recombinant |
| 浓度 | 1mg/ml |
| 储存液 | 0.01M TBS (pH7.4) with 1% BSA, 0.02% Proclin300 and 50% Glycerol. |
| 研究领域 | Cancer > Cancer Metabolism > Metabolic signaling pathway > Metabolism of lipids and lipoproteins Cancer > Cancer Metabolism > Response to hypoxia Metabolism > Pathways and Processes > Metabolic signaling pathways > Lipid and lipoprotein metabolism > Lipid metabolism Metabolism > Pathways and Processes > Metabolism processes > Hypoxia Metabolism > Types of disease > Cancer Signal Transduction > Cytoskeleton / ECM > Extracellular Matrix > ECM Proteins > Collagen Signal Transduction > Protein Trafficking > Chaperones > Other Chaperones Tags & Cell Markers > Subcellular Markers > Organelles > ER |
| 亚基 | Homodimer. Monomers and homotetramers may also occur. Also constitutes the structural subunit of prolyl 4-hydroxylase and of the microsomal triacylglycerol transfer protein MTTP in mammalian cells. Stabilizes both enzymes and retain them in the ER without contributing to the catalytic activity (By similarity). Binds UBQLN1. Binds to CD4, and upon HIV-1 binding to the cell membrane, is part of a P4HB/PDI-CD4-CXCR4-gp120 complex. |
| 亚细胞定位 | Endoplasmic reticulum lumen. Melanosome. Cell membrane; Peripheral membrane protein (Potential). Note=Highly abundant. In some cell types, seems to be also secreted or associated with the plasma membrane, where it undergoes constant shedding and replacement from intracellular sources (Probable). Localizes near CD4-enriched regions on lymphoid cell surfaces. Identified by mass spectrometry in melanosome fractions from stage I to stage IV. |
| 组织特异性 | Detected in the flagellum and head region of spermatozoa (at protein level). |
| 相似性 | Belongs to the protein disulfide isomerase family.
Contains 2 thioredoxin domains. |
| 功能 | This multifunctional protein catalyzes the formation, breakage and rearrangement of disulfide bonds. At the cell surface, seems to act as a reductase that cleaves disulfide bonds of proteins attached to the cell. May therefore cause structural modifications of exofacial proteins. Inside the cell, seems to form/rearrange disulfide bonds of nascent proteins. At high concentrations, functions as a chaperone that inhibits aggregation of misfolded proteins. At low concentrations, facilitates aggregation (anti-chaperone activity). May be involved with other chaperones in the structural modification of the TG precursor in hormone biogenesis. Also acts a structural subunit of various enzymes such as prolyl 4-hydroxylase and microsomal triacylglycerol transfer protein MTTP. |
| 保存条件 | Shipped at 4℃. Store at -20℃ for one year. Avoid repeated freeze/thaw cycles. |
| 注意事项 | This product as supplied is intended for research use only, not for use in human, therapeutic or diagnostic applications. |
| 背景资料 | P4HB, Prolyl 4 hydroxylase subunit beta, is a multifunctional and highly abundant enzyme that belongs to the protein disulfide isomerase family. When present as a tetramer consisting of two alpha and two beta subunits, this enzyme is involved in hydroxylation of prolyl residues in preprocollagen. This enzyme is also a disulfide isomerase containing two thioredoxin domains that catalyze the formation, breakage and rearrangement of disulfide bonds. |
| 应用 | 推荐稀释比例 |
| {WB} | {1:500-1000} |
| {IHC-P} | {1:100-500} |
| {IHC-F} | {1:100-500} |
| {ICC/IF} | {1:50-100} |
| {IF} | {1:100-500} |

风险提示:丁香通仅作为第三方平台,为商家信息发布提供平台空间。用户咨询产品时请注意保护个人信息及财产安全,合理判断,谨慎选购商品,商家和用户对交易行为负责。对于医疗器械类产品,请先查证核实企业经营资质和医疗器械产品注册证情况。
技术资料暂无技术资料 索取技术资料





